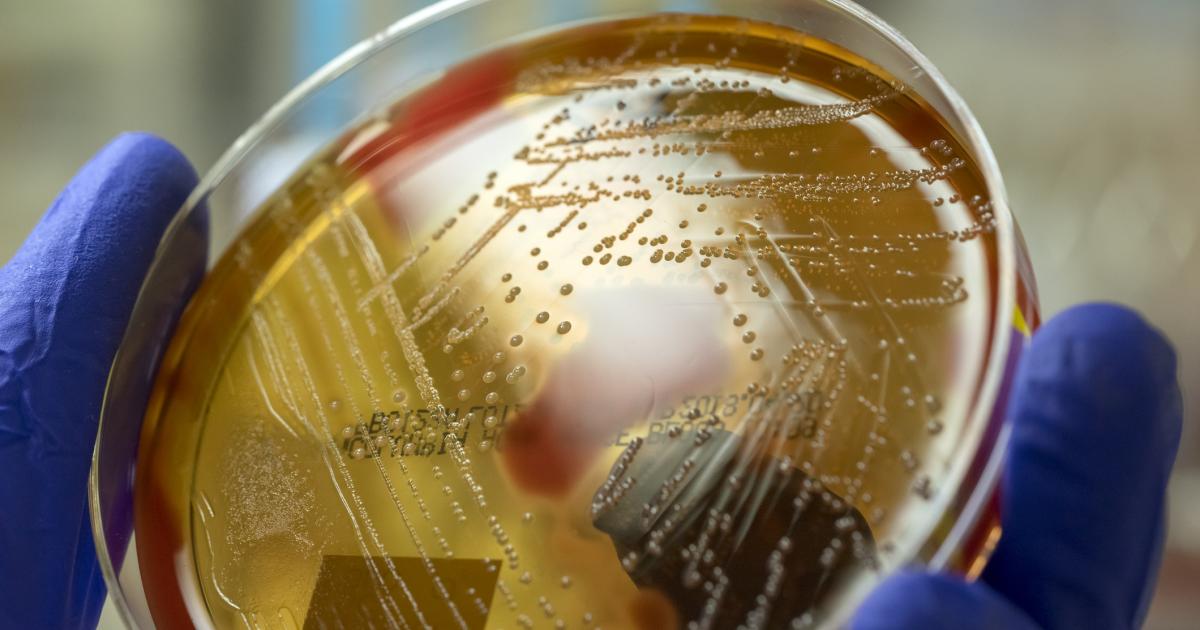
Imagen de archivo de un cultivo de Streptococcus pyogenes.

Una microbióloga aclara si en España hay que preocuparse por el estreptococo que se expande en Japón
La portavoz de la Sociedad Española de Enfermedades Infecciosas y Microbiología Clínica y microbióloga del Hospital de A Coruña, María del Mar Tomás, aclara las dudas más frecuentes.

En los últimos días, las noticias se han llenado de titulares sobre una rara cepa de estreptococo tipo A que se está expandiendo por Japón y que cuenta con un 30% de mortalidad si se desarrolla lo que se conoce como shock tóxico estreptocócico (STSS).
Las cifras publicadas por el Instituto Nacional de Enfermedades Infecciosas (NIID) mostraron 941 casos de STSS en 2023 y en los dos primeros meses de 2024 se han registrado 378 casos en 45 de las 47 prefecturas de Japón, por lo que se espera que se superen los datos del ejercicio anterior.
Desde el NIID han dejado claro que no tienen una causa determinada para este aumento de casos y que "todavía hay muchos factores desconocidos con respecto a los mecanismos detrás de las formas fulminantes (graves y repentinas) de estreptococos".
Un serotipo especialmente virulento y la reducción de las medidas covid
La portavoz de la Sociedad Española de Enfermedades Infecciosas y Microbiología Clínica y microbióloga del Hospital de A Coruña, María del Mar Tomás, ha señalado a El HuffPost que consideran que este aumento se debe a una causa "multifactorial".
"Por un lado se asocia al periodo postcovid en el que se han levantado las medidas restrictivas, se han quitado las mascarillas y puede dejar una deuda inmunológica que hace que te afecten más las infecciones provocadas por este patógeno. De hecho, en menores de 50 años no tendría que provocar una patología grave, sino que provoca una infección de garganta, de tracto respiratorio superior, etc.", explica.
Detalla que puede provocar otras localizaciones y casos más graves como sepsis, neumonía, meningitis o la fascitis necrotizante pero que va asociado a una mayor edad y a comorbilidades. "Sí que puede provocar el síndrome de shock tóxico que sí que es una afectación sistémica que puede provocar mortalidad en un 30% de los casos, pero estaría asociada a pacientes mayores o menores muy pequeños o inmunodeprimidos", detalla.
Entre los otros factores que han podido provocar este aumento detalla que Reino Unido ha detectado ya un serotipo de este estreptococo denominado M1UK que "puede producir más toxinas y provocar formas más graves de enfermedad". Sin embargo, la experta cree que está asociado a otros factores ya que "este serotipo en una persona inmunocompetente no tendría que provocar esta sepsis ni este shock séptico o neumonía". "Pero se necesitan más estudios e información al respecto", concluye.
¿Hay que preocuparse en España?
Sobre si esta infección podría llegar a España, Tomás hace un llamamiento a la calmar ya que indica que "no parece que exista esta tendencia tan alarmante de este número de casos". "No ha habido ninguna alarma de la Sociedad Española de Pediatría ni de ninguna sociedad científica al respecto, parece que en España no se está dando esta alarma", indica.
Sin embargo, sí que recomienda que haya una vigilancia epidemiológica, especialmente en "menores de cinco años", a pesar de no ser una enfermedad de declaración obligatoria, lo que dificulta la recopilación de datos. Además, recuerda que hay que tener medidas de prevención como lavado de manos, evitar el contacto con personas de riesgo si se tienen síntomas o la vacunación de gripe en otoño en menores de cinco años "porque esta bacteria puede provocar una sobreinfección tras una infección por gripe y evitaría también complicaciones".
Tomás recuerda que en España se ha detectado el serotipo "clásico", el M1, pero podría secuenciarse la variante M1UK. "Los laboratorios de microbiología en España tienen sistemas de secuenciación y podrían detectarlos con una secuenciación aleatoria", señala.